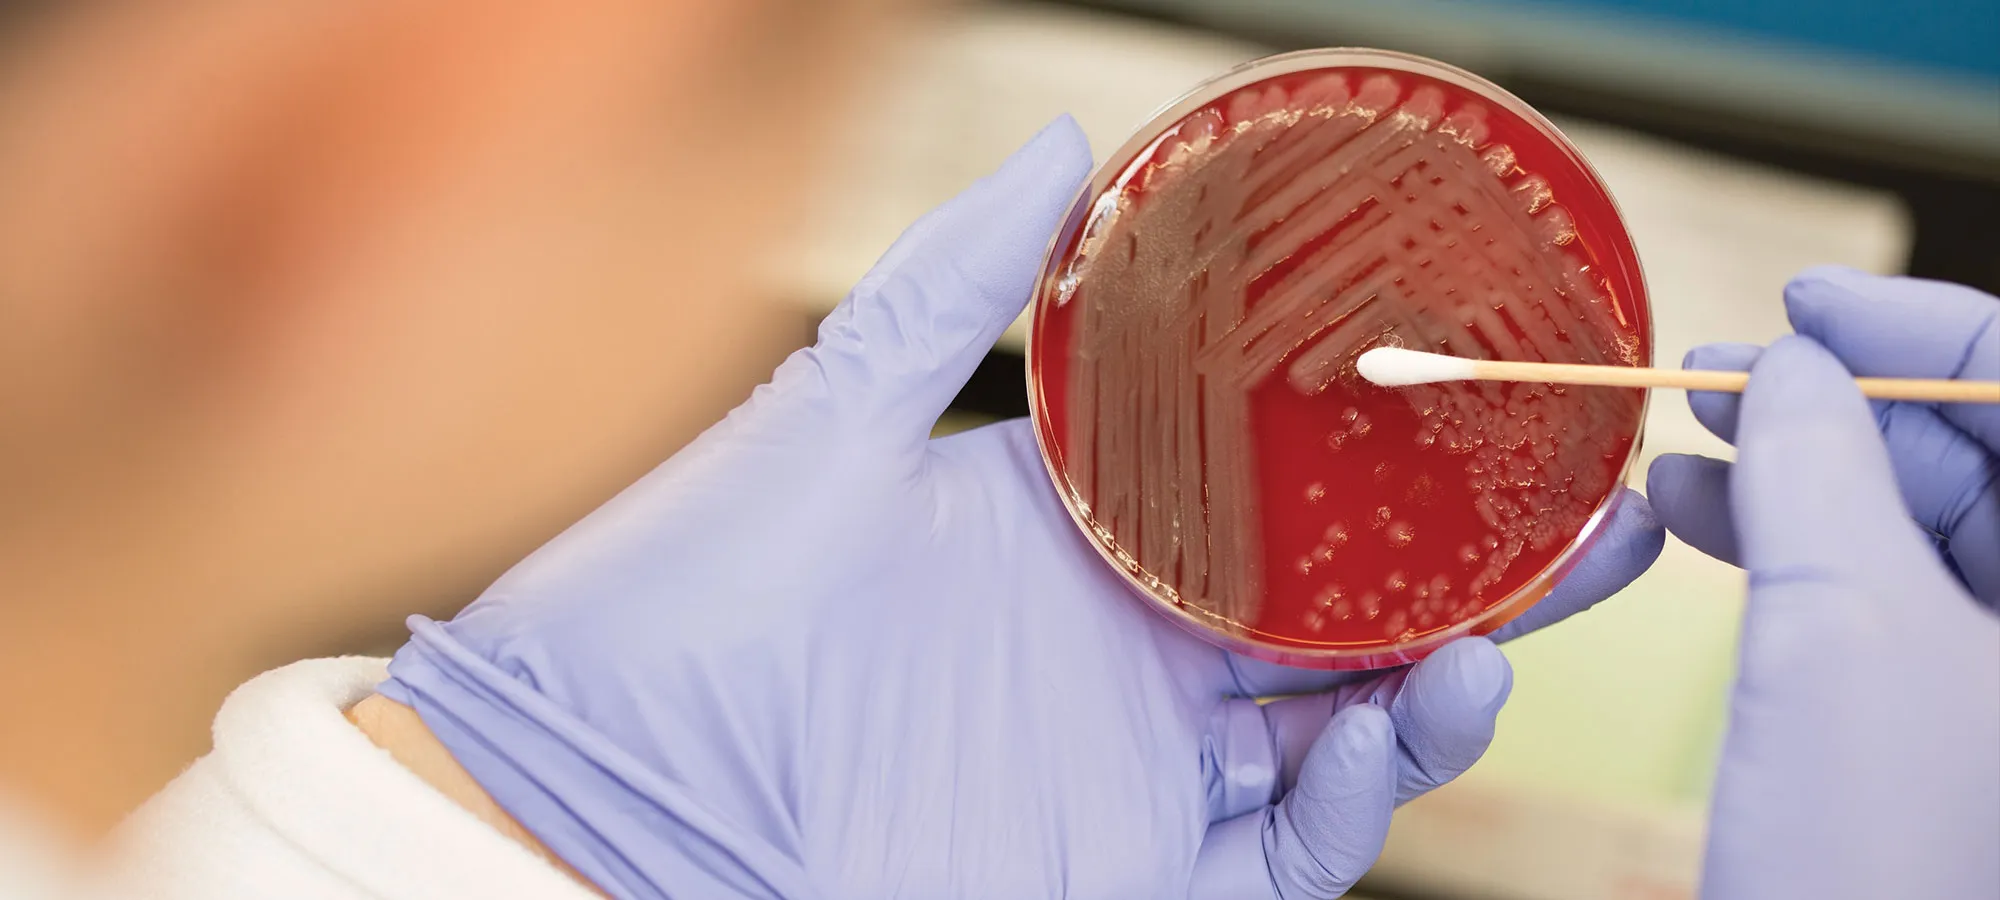

Testing Supplies
Use our online order form to request new supplies. Federal regulation requires that we only supply those supplies directly related to the testing performed at the Pathology Center.

Use our online order form to request new supplies. Federal regulation requires that we only supply those supplies directly related to the testing performed at the Pathology Center.

View detailed test collection information including specimen requirements, test methodologies, expected turn-around times and reference intervals


The Medical Laboratory Science (MLS) Program at Methodist Hospital offers an intensive 11-month educational program.